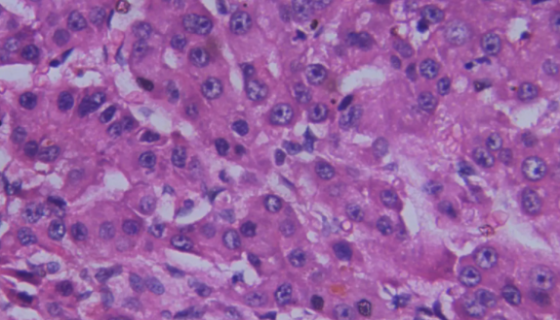
人肝癌细胞亚型的处理方法与培养步骤及注意事项！

原始编号:IFO 14064奇迹束丝放线菌打管说明!
奇迹束丝放线菌的注意事项及培养说明!

小鼠肾小管上皮细胞的生物学特性与实验方法!
肾小管与肾小囊壁层相连的一条细长上皮性小管,具有重吸收和排泌...
人肝癌细胞亚型的处理方法与培养步骤及注意事项!
人肝癌细胞亚型,由Omasa, T. & Suga, K发现...

烟曲霉的培养条件与注意事项及冻干管打管说明!
烟曲霉(拉丁名为Aspergillus fumigatus)...

NIH/3T3小鼠胚胎成纤维细胞的培养与处理方法!
小鼠胚胎成纤维细胞,与原始的随机交配3T3和近交系BALB/...

ATCC 31412 副血链球菌 百欧博伟生物
副血链球菌,仅用于科学研究或者工业应用等非医疗目的不可用于人...

龟裂链霉菌龟裂亚种安瓿瓶冻干管打管说明书!
龟裂链霉菌龟裂亚种是Streptomyces属的微生物,原产...

人腹膜间皮细胞的复苏与传代及冻存操作说明!
人腹膜间皮细胞分离自腹膜组织;腹膜是存在于高等脊椎动物腹腔中...

ATCC 43138 豕链球菌的背景与概述及防治与保藏方法!
豕链球菌(Streptococcus porcinus)是乳...